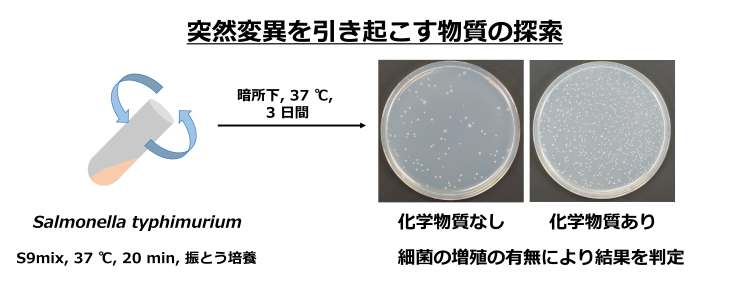
Ames test is a widely used genotoxicity assay with bacteria

Laboratory of Environmental Toxicology and Carcinogenesis
Faculty of Applied Pharmaceutical Sciences
Elucidation of the pathogenic mechanisms of diseases caused by environmental factors and development of preventive strategies
Exposure to environmental chemicals can cause various diseases, including cancer. We are conducting research to elucidate the mechanisms of cancer development caused by environmental factors and inflammation, and develop preventive strategies based on these findings. Our research uses a wide range of methods, including genotoxicity test using bacteria, cultured cells, and laboratory animals, comprehensive analysis of DNA damage/genomic mutation, and behavior analysis of protein.
Ames test is a widely used genotoxicity assay with bacteria
STAFF
- Professor Koichi Kato
- Professor Junichi nakajima
- Assistant Professor Kohei Watanabe





